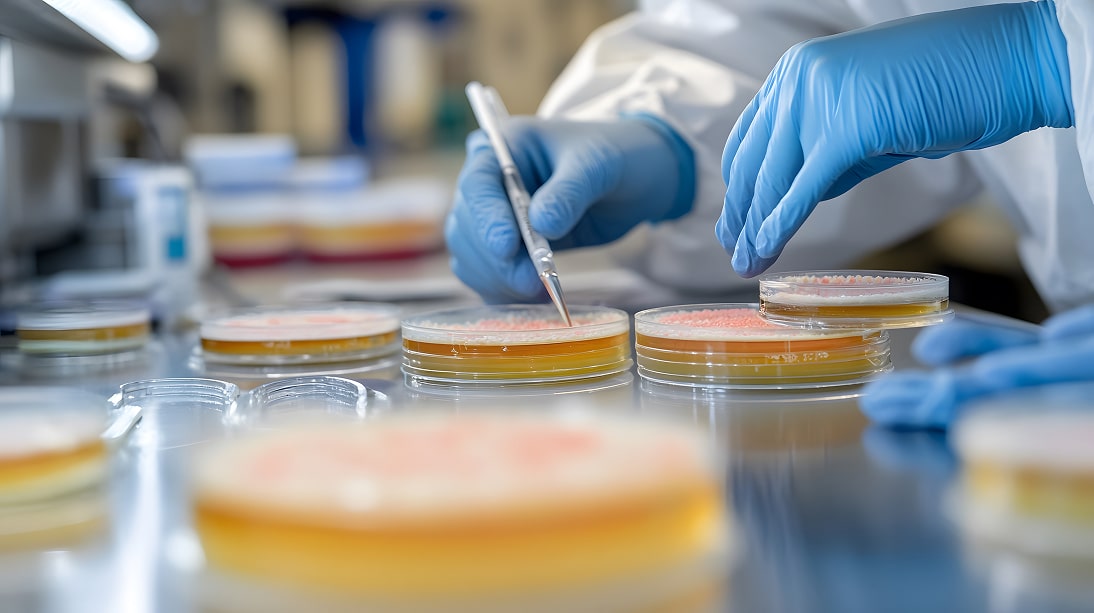

Haben Sie Verdauungsprobleme oder Hautbeschwerden? Wir sind für Sie da!
Schnelle Diagnose und Behandlung bei mikrobiellen Infektionen in Berlin
- Kompetente Diagnose & individuelle Therapie
- Spezialisten für Candida-Infektionen, Parasiten und Mikrobiom-Gesundheit
- Zentral in Berlin – schnelle Terminvergabe
- Umfassende mikrobiologische Tests
- Ganzheitlicher Behandlungsansatz
- Individuelle Betreuung durch erfahrene Ärzte
- Keine Wartezeiten
Vereinbaren Sie noch heute Ihre Mikrobiologische Untersuchung!
Jetzt online Termin buchenWas ist eine Mikrobiologische Untersuchung?
Mikrobiologische Untersuchung ist eine wissenschaftlich fundierte Methode, mit der krankmachende Mikroorganismen wie Bakterien, Hefen und Parasiten im Körper identifiziert werden. Diese Tests sind entscheidend, um Ursachen für wiederkehrende Beschwerden wie Candida Infektionen, Verdauungsstörungen und Hautprobleme zu erkennen. In unserer mikrobiologischen Diagnostik in Berlin bieten wir Ihnen präzise Untersuchungen, um die Ursachen Ihrer gesundheitlichen Beschwerden zu identifizieren und gezielt zu behandeln.

Typische Symptome einer Candida-Infektion
und anderer Mikroben im Körper
Viele Patienten wissen nicht, dass ihre Symptome auf Candida Infektionen oder andere mikrobielle Störungen zurückzuführen sind. Häufige Beschwerden, die durch Mikroben wie Hefen, Bakterien oder Parasiten verursacht werden, umfassen:

- Magen-Darm-Beschwerden
Blähungen, Sodbrennen, Verstopfung oder Durchfall - Hautprobleme
Ekzeme, Akne, Hautausschläge - Schlafstörungen
Müdigkeit, Schlaflosigkeit - Gelenk- und Muskelschmerzen
- Wiederkehrende Infektionen
Harnwegsinfektionen, Vaginale Infektionen
Wenn Sie diese Symptome bemerken, kann eine mikrobiologische Untersuchung
die Ursache aufdecken und eine gezielte Behandlung ermöglichen.
Warum ist eine Mikrobiologische Untersuchung wichtig?
Mikrobiologische Untersuchungen sind der Schlüssel zur Aufdeckung von Infektionen, die häufig übersehen werden. Viele Menschen leiden unter Candida Infektionen oder anderen mikrobiellen Erkrankungen, ohne es zu wissen. Unbehandelt können diese Mikroben erhebliche Schäden im Körper verursachen, etwa durch die Beeinträchtigung der Darmflora und des Mikrobioms. Eine mikrobiologische Untersuchung der Darmflora hilft dabei, festzustellen, ob das Mikrobiom im Ungleichgewicht ist und ob Candida albicans oder andere pathogene Hefen die Ursache Ihrer Beschwerden sind.
Jetzt, da wir die Wichtigkeit einer Mikrobiologischen Untersuchung verstehen, werfen wir einen Blick auf die spezifischen Tests, die wir durchführen, um diese versteckten Mikroben zu identifizieren.

Unsere Mikrobiologische
Untersuchung – Was wir testen
Unsere mikrobiologische Untersuchung umfasst die Analyse einer Vielzahl von
Mikroben, die sich im Körper befinden können. Wir testen auf
- Candida albicans und andere pathogene Hefen, die viele gesundheitliche Probleme verursachen können
- Parasiten, die oft unentdeckt bleiben, aber Magen-Darm Probleme und andere chronische Erkrankungen auslösen können
- Bakterien (z. B. pathogene Keime, die das Mikrobiom im Darm stören)
- Mikrobiom-Analyse, um das Gleichgewicht der Darmflora zu überprüfen und mögliche Störungen zu identifizieren
- Mykotoxine, die von Hefen wie Candida produziert werden und den Körper belasten können
Warum sollten Sie uns für Ihre
Mikrobiologische Untersuchung wählen?
Erfahrene Fachärzte für Mikrobiologie
Unsere Ärzte sind Experten auf dem Gebiet der mikrobiologischen Diagnostik und bieten Ihnen eine präzise und gründliche Untersuchung.
Moderne Labortechnologie
Wir nutzen die neuesten Technologien zur Analyse von Hefen, Bakterien und Parasiten in Ihrem Körper.
Individuelle Behandlung
Auf Basis der Ergebnisse aus der Mikrobiom Analyse und anderen Tests bieten wir Ihnen eine maßgeschneiderte Behandlung, die Ihre Gesundheit langfristig verbessert.
Wie läuft eine Mikrobiologische Untersuchung ab?
- Erstgespräch und Anamnese
Wir beginnen mit einem detaillierten Gespräch, um Ihre Symptome zu verstehen. - Probenentnahme
Für die mikrobiologische Untersuchung nehmen wir Proben aus Ihrem Stuhl, Ihrer Haut oder Schleimhäuten. - Analyse der Proben
Im Labor analysieren wir die Proben auf Candida albicans, Parasiten, Bakterien und andere Mikroben. - Wiederkehrende Infektionen
Nach der Analyse stellen wir Ihnen eine maßgeschneiderte Behandlung vor.
Mikrobiologische Untersuchung – Was wir für Ihre Gesundheit tun
Unsere mikrobiologischen Untersuchungen bieten Ihnen eine präzise und umfassende Diagnose, die auf Ihre individuellen Gesundheitsbedürfnisse zugeschnitten ist. Durch die Analyse von Hefepilzen wie Candida albicans, Parasiten und anderen Mikroben im Körper können wir die Ursachen Ihrer Beschwerden aufdecken und gezielte Behandlungsmöglichkeiten vorschlagen.
Unsere Leistungen umfassen

Candida Infektionen
Mithilfe unserer mikrobiologischen Untersuchung können wir festzustellen, ob Candida albicans oder andere Hefepilze die Ursache für Ihre gesundheitlichen Probleme sind.

Parasitenuntersuchung
Wir analysieren Ihren Körper auf Parasiten, die häufig unentdeckt bleiben und Magen-Darm-Probleme sowie andere gesundheitliche Beschwerden verursachen.

Mikrobiom Analyse
Eine Untersuchung Ihres Mikrobioms hilft, das Gleichgewicht der Darmflora zu überprüfen. Eine gestörte Darmflora kann zu Verdauungsstörungen, Hautproblemen und anderen chronischen Erkrankungen führen.
Warum sollten Sie sich für uns entscheiden?
Sorgfältige Diagnostik
Jede mikrobiologische Untersuchung wird sorgfältig durchgeführt, um Ihnen eine genaue Diagnose zu liefern.
Individuelle Behandlung
Wir bieten eine maßgeschneiderte Behandlungsstrategie, die auf den Ergebnissen Ihrer mikrobiologischen Untersuchung basiert.
Ganzheitliche Betreuung
Unser Fokus liegt nicht nur auf Symptomen, sondern auch auf der Ursachenforschung, um dauerhafte Gesundheit zu gewährleisten.
Buchen Sie jetzt Ihre Mikrobiologische Untersuchung
Wenn Sie glauben, dass Ihre Beschwerden durch Candida Infektionen, Parasiten oder ein Ungleichgewicht in Ihrem Mikrobiom verursacht werden, dann buchen Sie jetzt einen Termin für eine mikrobiologische Untersuchung.
Unsere Experten in Berlin bieten Ihnen die genaueste Diagnostik und helfen Ihnen, die Ursache Ihrer Gesundheitsprobleme zu finden und zu behandeln.
Die Normamed Methode zur Behandlung von Candida Infektionen
Die Normamed Methode ermöglicht es, Candida Infektionen frühzeitig zu erkennen und gezielt zu behandeln.
Mit einer präzisen mikrobiologischen Untersuchung können wir die genaue Ursache feststellen und Ihre Gesundheit langfristig stabilisieren.
Für mehr Informationen über Candida albicans und Behandlungsmöglichkeiten, lesen Sie unseren Artikel.
Häufig gestellte Fragen- Mikrobiologische
Untersuchung & Mykologie in Berlin
Was ist eine mikrobiologische Untersuchung?
Eine mikrobiologische Untersuchung ist ein diagnostisches Verfahren, bei dem krankmachende Mikroorganismen wie Hefen, Bakterien und Parasiten im Körper identifiziert werden. Diese Tests sind entscheidend, um Ursachen für wiederkehrende Beschwerden wie Candida-Infektionen, Verdauungsstörungen und Hautprobleme zu erkennen. In unserer mikrobiologischen Diagnostik in Berlin bieten wir Ihnen präzise Untersuchungen, um die Ursachen Ihrer gesundheitlichen Beschwerden zu identifizieren und gezielt zu behandeln.
Welche Symptome deuten auf eine Candida-Infektion hin?
Typische Symptome einer Candida-Infektion und anderer Mikroben im Körper sind:
- Magen-Darm-Beschwerden: Blähungen, Sodbrennen, Verstopfung oder Durchfall
- Hautprobleme: Ekzeme, Akne, Hautausschläge
- Schlafstörungen: Müdigkeit, Schlaflosigkeit
- Gelenk- und Muskelschmerzen
- Wiederkehrende Infektionen: Harnwegsinfektionen, vaginale Infektionen
Wenn Sie diese Symptome bemerken, kann eine mikrobiologische Untersuchung die Ursache aufdecken und eine gezielte Behandlung ermöglichen.
Welche Tests werden bei einer mikrobiologischen Untersuchung durchgeführt?
Unsere Mikrobiologische Untersuchung umfasst die Analyse einer Vielzahl von Mikroben, die sich im Körper befinden können. Wir testen auf:
- Candida albicans und andere pathogene Hefen, die viele gesundheitliche Probleme verursachen können
- Parasiten, die oft unentdeckt bleiben, aber Magen-Darm-Probleme und andere chronische Erkrankungen auslösen können
- Bakterien (z. B. pathogene Keime, die das Mikrobiom im Darm stören)
- Mikrobiom-Analyse, um das Gleichgewicht der Darmflora zu überprüfen und mögliche Störungen zu identifizieren
Mykotoxine, die von Hefen wie Candida produziert werden und den Körper belasten können
Warum sollte ich mich für Ihre mikrobiologische Untersuchung entscheiden?
Unsere Mikrobiologische Untersuchung bietet Ihnen:
- Erfahrene Fachärzte für Mikrobiologie
- Moderne Labortechnologie zur Analyse von Hefen, Bakterien und Parasiten
- Individuelle Behandlung basierend auf den Ergebnissen aus der Mikrobiom-Analyse und anderen Tests
- Ganzheitliche Betreuung mit Fokus auf Ursachenforschung
Wie läuft eine mikrobiologische Untersuchung ab?
Der Ablauf einer mikrobiologischen Untersuchung umfasst:
- Erstgespräch und Anamnese: Ein detailliertes Gespräch, um Ihre Symptome zu verstehen.
- Probenentnahme: Entnahme von Proben aus Ihrem Stuhl, Ihrer Haut oder Schleimhäuten.
- Analyse der Proben: Im Labor werden die Proben auf Candida albicans, Parasiten, Bakterien und andere Mikroben analysiert.
- Individuelle Behandlungsempfehlung: Nach der Analyse erhalten Sie eine maßgeschneiderte Behandlung.
Wo befindet sich unsere Praxis in Berlin?
Unsere Praxis für mikrobiologische Untersuchungen befindet sich zentral in Berlin, sodass Sie uns schnell und unkompliziert erreichen können. Wir bieten schnelle Terminvergaben und individuelle Betreuung durch erfahrene Ärzte.
Wie kann ich einen Termin für eine mikrobiologische Untersuchung vereinbaren?
Sie können Ihren Termin ganz einfach online buchen. Klicken Sie dazu auf den folgenden Link:
Warum ist eine mikrobiologische Untersuchung für Candida-Infektionen wichtig?
Eine mikrobiologische Untersuchung hilft, Candida-Infektionen zu diagnostizieren und die genauen Ursachen Ihrer Beschwerden zu erkennen. Wir verwenden moderne Mikrobiologie-Diagnostik, um festzustellen, ob Candida albicans oder andere Hefepilze die Ursache Ihrer gesundheitlichen Probleme sind. Eine präzise Diagnose ermöglicht eine zielgerichtete Behandlung und die Wiederherstellung des gesunden Mikrobioms.